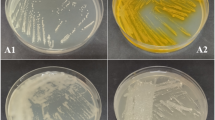

Abstract
ACCORDING to the UN Food and Agricultural Organisation production year book of 1974, 27×106 kg of the herbicide 2,4-dichlorophenoxyacetic acid (2,4-D) were consumed in 1973, making this the most extensively used of all pesticides. One desirable characteristic of 2,4-D, apart from its efficacy as a herbicide, is its lack of persistence in the environment1, due to degradation by a variety of microorganisms. We have argued that in view of the isolation of plasmids encoding the degradation of naturally occurring aliphatic and aromatic compounds2, there exists a class of plasmids which specifically encode the degradation of many man-made derivatives of these compounds, in this instance 2,4-D. Using segregation and transfer analyses we have demonstrated that a plasmid or plasmids is involved in 2,4-D degradation. Clearly bacteria have evolved which can degrade many different pesticides; our results indicate that plasmids may have an important role in this evolution.
This is a preview of subscription content, access via your institution
Access options
Subscribe to this journal
Receive 51 print issues and online access
$199.00 per year
only $3.90 per issue
Buy this article
- Purchase on SpringerLink
- Instant access to full article PDF
Prices may be subject to local taxes which are calculated during checkout
Similar content being viewed by others
References
Alexander, M. Soil Biology, Reviews of Research, Natural Resources Research, Unesco 9, 209–240 (1969).
Chakrabarty, A. M. A. Rev. Genet. 10, 7–30 (1976).
Loos, M. A. Can. J. Microbiol. 21, 104–107 (1975).
Burger, K., MacRae, I. C. & Alexander, M. Proc. Am. Soil Soc. 26, 243–246 (1962).
Lacy, R. W. Bact. Rev. 39, 1–32 (1975).
Stanisich, V. A. J. gen. Microbiol. 84, 332–342 (1974).
Haas, D. & Holloway, B. W. Molec. gen. Genet. 144, 243–351 (1976).
Torstensson, N. T. L., Stark, J. & Goransson, B. Weed Res. 15, 159–164 (1975).
Author information
Authors and Affiliations
Rights and permissions
About this article
Cite this article
PEMBERTON, J., FISHER, P. 2,4-D plasmids and persistence. Nature 268, 732–733 (1977). https://doi.org/10.1038/268732a0
Received:
Accepted:
Issue date:
DOI: https://doi.org/10.1038/268732a0
This article is cited by
-
Pesticide relevance and their microbial degradation: a-state-of-art
Reviews in Environmental Science and Bio/Technology (2014)
-
Construction of an engineered strain capable of degrading two isomeric nitrophenols via a sacB- and gfp-based markerless integration system
Applied Microbiology and Biotechnology (2014)
-
The Behavior of Bacteria Designed for Biodegradation
Nature Biotechnology (1994)
-
Characterization of a carbofuran-degrading bacterium and investigation of the role of plasmids in catabolism of the insecticide carbofuran
Archives of Microbiology (1992)
-
Degradation of 2,4-dichlorophenoxyacetic acid by mixed cultures of bacteria
Journal of Industrial Microbiology (1990)